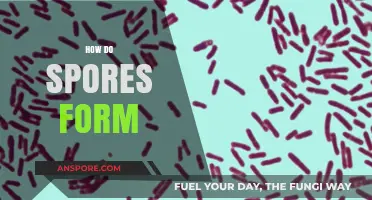
Understanding the Fascinating Process of How Spores Develop and Form

Spore blossoms, often associated with fungi and certain plants, are fascinating structures designed to disperse spores efficiently into the environment. Unlike seeds, spores are microscopic reproductive units that can develop into new organisms under favorable conditions. Spore blossoms typically feature intricate, often delicate structures that maximize surface area and exposure to air currents. When mature, these blossoms release spores through mechanisms such as wind, water, or even explosive discharge, ensuring widespread dispersal. This process is crucial for the survival and propagation of spore-producing organisms, as it allows them to colonize new habitats and thrive in diverse ecosystems. Understanding how spore blossoms work provides insight into the remarkable strategies nature employs for reproduction and survival.
| Characteristics | Values |
|---|---|
| Type of Reproduction | Asexual (vegetative reproduction) |
| Organism Type | Primarily found in ferns, liverworts, and some lycophytes |
| Structure | Small, cup-like or sac-like structures typically located on the underside of leaves or on specialized structures |
| Spore Production | Each spore blossom produces numerous spores through mitosis |
| Spore Release Mechanism | Spores are released through a small opening (ostiole) often triggered by environmental factors like humidity or rain |
| Dispersal | Spores are dispersed by wind, water, or animals |
| Germination | Spores germinate under suitable conditions to form a new individual (prothallus in ferns) |
| Function | Rapid vegetative propagation, colonization of new habitats, and survival in adverse conditions |
| Examples | Ferns (e.g., spleenworts), liverworts (e.g., Marchantia), and some lycophytes |
| Environmental Adaptation | Efficient for spreading in moist, shaded environments where sexual reproduction may be less feasible |
| Comparison to Sporangia | Smaller and simpler than sporangia, often producing fewer spores but in more compact structures |
Explore related products
What You'll Learn
- Spore release mechanisms: how and when spores are dispersed from the blossom
- Blossom structure: anatomy and function of spore-producing parts in the flower
- Environmental triggers: factors like humidity, light, and temperature that activate spore release
- Spore viability: conditions needed for spores to germinate and grow successfully
- Evolutionary adaptations: how spore blossoms have evolved to thrive in specific ecosystems

Spore release mechanisms: how and when spores are dispersed from the blossom
Spore blossoms, often associated with fungi and certain plants, have evolved intricate mechanisms to ensure the efficient dispersal of spores, a critical process for their reproduction and survival. One of the most fascinating methods is the active discharge mechanism, commonly observed in fungi like the puffball or the cannonball fungus. When mature, these structures build up internal pressure, and upon reaching a threshold, they release spores in a sudden, explosive burst. This mechanism can propel spores several feet, significantly increasing their chances of finding new habitats. For instance, the *Pilobolus* fungus uses a unique, light-sensitive system to aim its spore discharge toward light sources, often the forest canopy, ensuring optimal dispersal.
In contrast, some spore blossoms rely on passive mechanisms, leveraging environmental factors like wind, water, or animals for dispersal. Ferns, for example, produce spores in structures called sporangia, which dry out and split open, releasing spores into the air. This process is highly dependent on weather conditions—dry, windy days maximize dispersal. Similarly, mosses release spores from capsules that open through a lid-like structure, relying on wind currents to carry them away. While less dramatic than active mechanisms, these passive methods are energy-efficient and effective in the right conditions.
Timing is crucial in spore release, often synchronized with environmental cues to maximize success. Many fungi release spores at night, taking advantage of cooler temperatures and higher humidity, which help spores remain viable during dispersal. For example, the *Coprinus comatus* (shaggy mane mushroom) releases spores in the early morning, coinciding with dew formation, which aids in spore adhesion to surfaces. In contrast, some plants, like certain ferns, release spores during the dry season, ensuring they land in environments conducive to germination. Understanding these timing strategies can help gardeners and conservationists optimize conditions for spore-bearing species.
Practical applications of spore release mechanisms are evident in horticulture and mycology. For instance, mushroom cultivators mimic natural conditions by maintaining high humidity and controlled light to induce spore release in fungi. Similarly, fern enthusiasts use trays of moist soil and plastic domes to create a humid microclimate, encouraging spore germination. A useful tip for home gardeners: place a mature fern frond with sporangia on a damp paper towel in a sealed container for 24 hours to collect spores, which can then be sown in a sterile medium for propagation.
Comparing active and passive spore release mechanisms highlights the diversity of evolutionary strategies in spore blossoms. While active mechanisms offer precision and force, passive methods rely on simplicity and environmental synergy. Both approaches underscore the adaptability of spore-producing organisms to their ecosystems. By studying these mechanisms, scientists and enthusiasts alike can better appreciate the complexity of spore dispersal and apply this knowledge to conservation, agriculture, and even biomimicry in engineering. Whether through a fungal explosion or a fern’s gentle release, spore blossoms demonstrate nature’s ingenuity in ensuring the next generation’s survival.
How to Legally Obtain Spore for Free: Tips and Tricks
You may want to see also

Blossom structure: anatomy and function of spore-producing parts in the flower
Spore-producing blossoms, unlike their seed-bearing counterparts, are marvels of efficiency, designed to disperse genetic material with minimal energy investment. At the heart of this process lies the sporangium, a sac-like structure nestled within the flower's reproductive organs. These sporangia house the spores, each a microscopic, single-celled unit capable of developing into a new organism under favorable conditions. Understanding the anatomy of these spore-producing parts is key to appreciating the intricate dance of plant reproduction.
Consider the antheridium and archegonium, often found in more primitive plants like ferns and mosses. The antheridium produces male gametes, while the archegonium nurtures the female egg. In spore blossoms, these structures are simplified, with sporangia taking center stage. For instance, in ferns, the sori—clusters of sporangia—are typically found on the underside of fronds, protected yet accessible for spore release. This strategic placement ensures that spores are dispersed efficiently, often with the aid of wind or water.
The function of these spore-producing parts is as fascinating as their structure. Sporangia undergo a process called meiosis, producing haploid spores that are genetically diverse. This diversity is crucial for adaptation, allowing plant species to thrive in varying environments. Once mature, the sporangia dry out, causing them to burst open and release spores into the air. This mechanism, known as dehiscent release, is a testament to nature's ingenuity, maximizing dispersal with minimal energy expenditure.
Practical observation of spore blossoms can be a rewarding endeavor. For enthusiasts, examining ferns under a magnifying glass reveals the intricate patterns of sori. For educators, demonstrating the lifecycle of mosses—from spore to gametophyte to sporophyte—offers a tangible lesson in plant biology. Gardeners can even cultivate spore-producing plants like ferns and lycopods, creating microcosms of spore dispersal in their own backyards. By understanding the anatomy and function of these structures, we gain a deeper appreciation for the silent, yet vital, role spore blossoms play in the natural world.
How to Obtain Spore Blossoms in Minecraft Survival Mode
You may want to see also

Environmental triggers: factors like humidity, light, and temperature that activate spore release
Spore blossoms, nature's ingenious dispersal mechanisms, rely heavily on environmental cues to release their spores effectively. Among these cues, humidity, light, and temperature stand out as critical triggers. Each factor interacts uniquely with the blossom's physiology, ensuring spores are released under optimal conditions for germination and survival. Understanding these triggers not only sheds light on plant biology but also offers insights into ecological adaptation and conservation strategies.
Consider humidity, a key player in spore release dynamics. Many spore blossoms, such as those of ferns and fungi, are hygroscopic, meaning they respond to moisture levels in the air. For instance, a relative humidity of 90% or higher often activates the opening of sporangia in ferns, allowing spores to disperse. This mechanism ensures spores are released into an environment conducive to absorption of water, a critical step for germination. Gardeners and conservationists can mimic these conditions by misting plants or using humidifiers to encourage spore release in controlled settings, particularly for species at risk of habitat loss.
Light, another environmental trigger, influences spore release through photoreceptors in plant tissues. Some spore blossoms, like those of certain mosses, are phototropic, responding to specific wavelengths of light. Blue light, for example, has been shown to stimulate spore discharge in species such as *Physarum polycephalum*, a type of slime mold. This adaptation ensures spores are released during daylight hours when conditions are favorable for dispersal by wind or water. For hobbyists cultivating spore-bearing plants indoors, using grow lights with a blue spectrum can enhance spore release, particularly during winter months when natural light is scarce.
Temperature plays a dual role in activating spore release, acting both as a direct trigger and an indirect influencer of other environmental factors. In species like the puffball fungus, a temperature range of 15°C to 25°C (59°F to 77°F) optimizes spore discharge. Extreme temperatures, however, can inhibit release or cause premature drying of spores. Researchers studying climate change impacts often monitor temperature thresholds for spore release, as shifts in global temperatures could disrupt reproductive cycles in spore-bearing plants. For home gardeners, maintaining a stable temperature within this range can improve the success of spore propagation efforts.
The interplay of these environmental triggers highlights the sophistication of spore blossoms' dispersal strategies. Humidity ensures spores land in moist environments, light synchronizes release with optimal dispersal times, and temperature fine-tunes the process for maximum efficiency. By manipulating these factors, whether in a laboratory, greenhouse, or natural habitat, humans can support the survival and propagation of spore-bearing species. This knowledge not only advances botanical science but also empowers conservation efforts in an era of environmental change.
Storing Mushroom Spores: Fridge or Not? A Complete Guide
You may want to see also
Explore related products

Spore viability: conditions needed for spores to germinate and grow successfully
Spores, the microscopic survival units of fungi, plants, and some bacteria, require precise conditions to transition from dormancy to active growth. This process, known as germination, hinges on a delicate interplay of environmental factors. Without the right combination of moisture, temperature, oxygen, and light, spores remain inert, biding their time until conditions align. Understanding these requirements is crucial for anyone cultivating spore-bearing organisms or managing environments where spore germination is undesirable.
The Role of Moisture and Temperature
Moisture is the catalyst that awakens dormant spores, triggering metabolic activity and initiating germination. For most fungal spores, a relative humidity above 90% is necessary, though some species tolerate lower levels. Water must be available in liquid form, as vapor alone is insufficient. Temperature acts as a secondary regulator, with optimal ranges varying by species. For example, *Aspergillus* spores thrive between 25°C and 30°C, while *Penicillium* prefers slightly cooler conditions, around 20°C to 25°C. Deviations from these ranges can delay or halt germination entirely. Practical tip: Use a hygrometer to monitor humidity and a thermostat-controlled environment to maintain precise temperatures when cultivating spore-based cultures.
Oxygen and Nutrient Availability
Unlike seeds, spores do not store extensive nutrient reserves, making external nutrient availability critical for successful growth. Organic matter, such as decaying plant material or soil rich in nitrogen, provides the essential nutrients spores need to develop. Oxygen is equally vital, as most spores require aerobic conditions to metabolize nutrients efficiently. Anaerobic environments stifle germination, though a few specialized species, like certain anaerobic bacteria, can bypass this requirement. Caution: Overcrowding spores in a confined space can deplete oxygen rapidly, so ensure adequate ventilation or substrate surface area.
Light and pH Considerations
While many spores are indifferent to light, some exhibit photodependence, germinating only in the presence or absence of specific wavelengths. For instance, certain fungal spores require near-ultraviolet light to trigger germination, a mechanism that ensures they activate under optimal surface conditions. pH levels also play a subtle role, with most spores preferring neutral to slightly acidic environments (pH 5.5–7.0). Extreme pH values can denature enzymes essential for germination. Practical tip: For light-sensitive spores, use opaque containers or store them in dark environments to prevent premature activation.
Practical Application and Takeaway
Mastering spore viability conditions is both an art and a science. Gardeners can enhance mushroom cultivation by pre-soaking spores in distilled water for 12–24 hours before inoculating substrate, ensuring adequate moisture absorption. In contrast, pest managers can inhibit fungal growth by maintaining indoor humidity below 60% and temperatures above 35°C, conditions unfavorable for most household mold spores. Whether fostering growth or preventing it, the key lies in manipulating these environmental factors with precision. By understanding the specific needs of the spores in question, one can either nurture their development or effectively suppress their activation.
Wandering Trader Spore Blossoms: Can You Obtain Them in Minecraft?
You may want to see also

Evolutionary adaptations: how spore blossoms have evolved to thrive in specific ecosystems
Spore blossoms, often associated with fungi and certain plant species, have developed remarkable evolutionary adaptations to ensure their survival and proliferation in diverse ecosystems. These adaptations are not merely coincidental but are finely tuned responses to environmental pressures, enabling spore blossoms to thrive where others might fail. By examining these adaptations, we can uncover the intricate strategies that have allowed them to dominate specific niches.
Consider the role of spore size and shape, a critical adaptation that varies widely across species. In wind-dispersed ecosystems, such as open grasslands or forests, spore blossoms produce lightweight, aerodynamic spores that can travel vast distances. For instance, ferns in temperate forests release spores with a diameter of 20–50 micrometers, optimized for wind capture. In contrast, spore blossoms in aquatic environments, like certain algae, develop heavier, gelatinous spores that sink efficiently, ensuring they reach the substrate where they can germinate. This specificity in spore design highlights how evolutionary pressures shape dispersal mechanisms to match the habitat.
Another key adaptation lies in the timing and triggers of spore release. In arid regions, spore blossoms often remain dormant until specific environmental cues, such as rainfall or humidity spikes, signal favorable conditions for growth. For example, desert lichens release spores only after rare rain events, maximizing the chances of successful colonization. Similarly, in fire-prone ecosystems, some fungi have evolved to release spores in response to heat or smoke, taking advantage of the nutrient-rich ash left behind. This strategic timing ensures that spores are not wasted during inhospitable periods, a crucial survival mechanism in unpredictable environments.
The structure of spore-bearing organs also reflects evolutionary ingenuity. In humid tropical rainforests, spore blossoms like those of certain mosses and liverworts develop splash cups or elongated stalks that use rainwater as a dispersal agent. These structures amplify the force of raindrops, propelling spores several meters away from the parent plant, reducing competition and increasing colonization opportunities. Conversely, in nutrient-poor environments, spore blossoms may invest in symbiotic relationships, such as mycorrhizal associations in fungi, to enhance nutrient uptake and survival.
Lastly, chemical adaptations play a pivotal role in spore blossom success. Some species produce spores coated with protective compounds that deter predators or resist desiccation. For instance, spores of certain fungi contain melanin, which provides UV resistance and structural integrity in harsh conditions. Others release spores with allelopathic chemicals that inhibit the growth of competing organisms, securing a foothold in crowded ecosystems. These biochemical strategies underscore the sophistication of spore blossoms’ evolutionary toolkit.
In practical terms, understanding these adaptations can inform conservation efforts and agricultural practices. For example, gardeners in arid regions can mimic natural triggers by watering spore-bearing plants during specific times to encourage germination. Similarly, forest managers can use knowledge of fire-triggered spore release to promote fungal diversity after controlled burns. By leveraging these evolutionary insights, we can foster environments where spore blossoms continue to thrive, contributing to ecosystem health and resilience.
Bypassing Spore Registration: Hacking Your Disc Legally and Safely Explained
You may want to see also
Frequently asked questions
Spore blossoms are specialized reproductive structures found in certain plants, fungi, or organisms that release spores into the environment for propagation.
Spore blossoms typically release spores through mechanisms like bursting, wind dispersal, or environmental triggers such as humidity or temperature changes.
The primary purpose of spore blossoms is to facilitate the reproduction and dispersal of spores, ensuring the survival and spread of the species.
No, spore blossoms are specific to certain types of plants (like ferns and mosses) and fungi, which reproduce via spores rather than seeds.
While most spore blossoms are harmless, some fungal spore blossoms can release allergens or toxins that may affect sensitive individuals or animals.